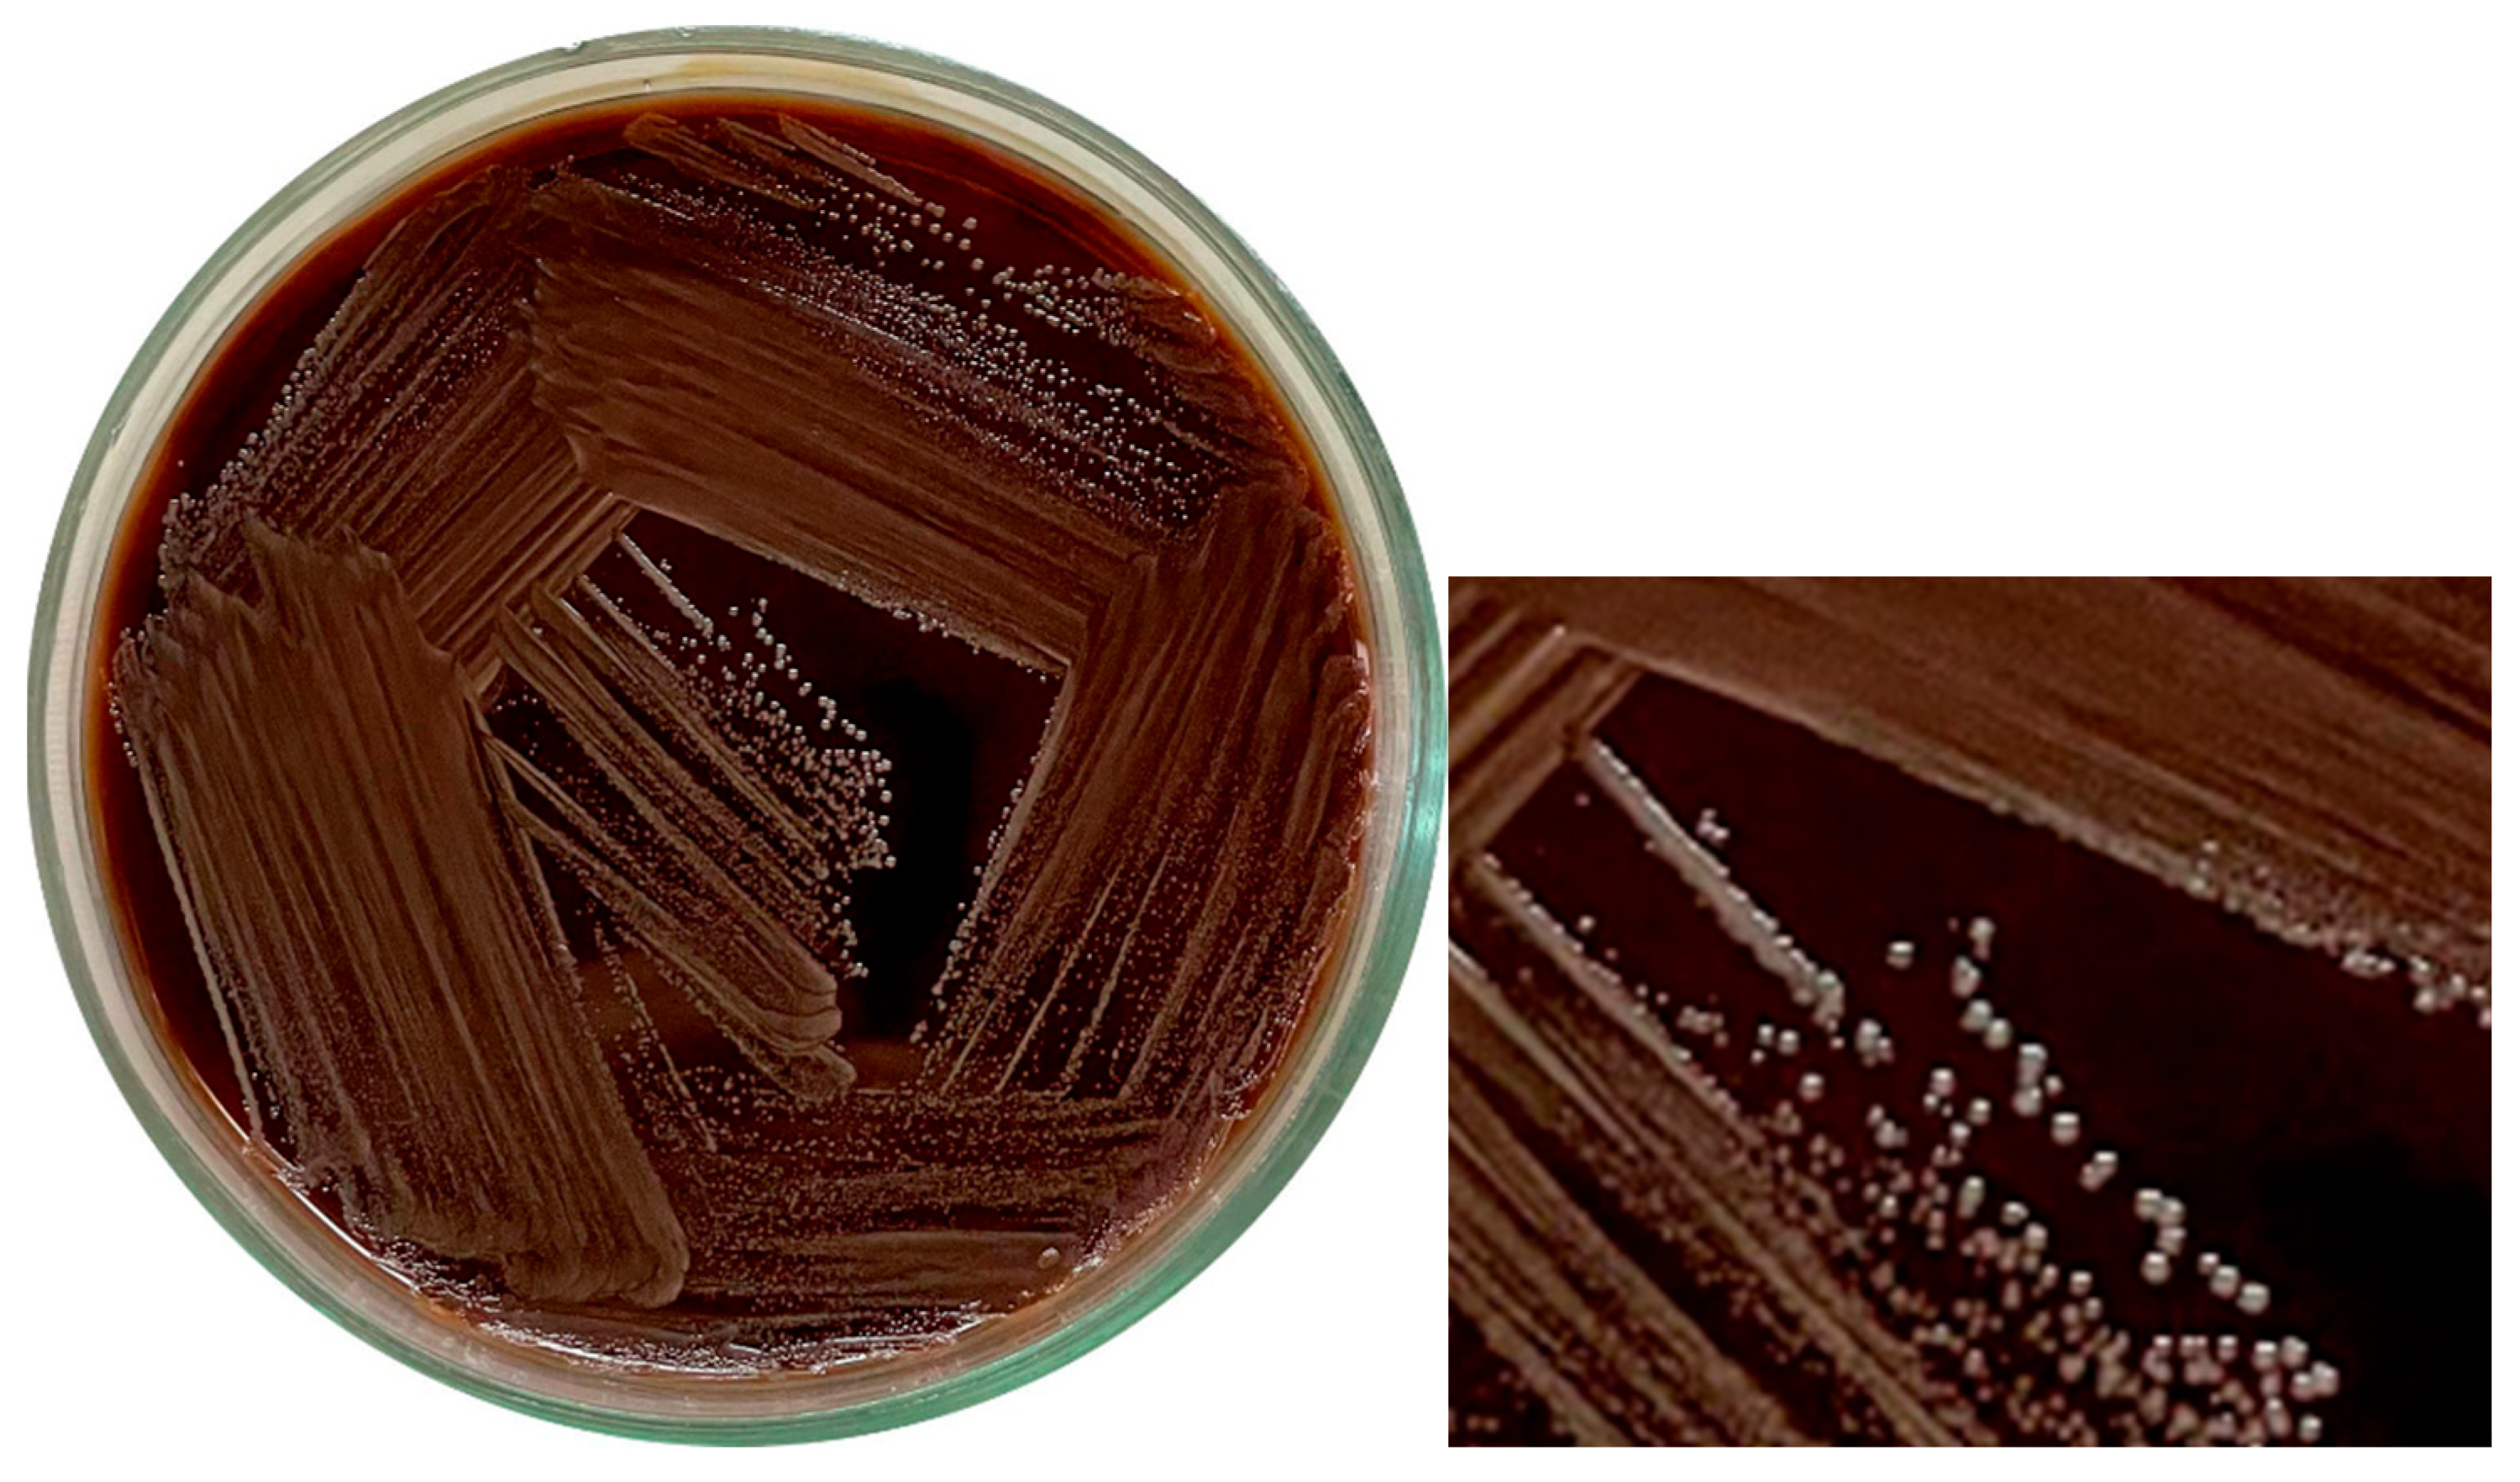
Microbiolres 16 00103 g002

Abstract
Atopobium vaginae (nowadays Fannyhessea vaginae) is an anaerobic bacterium increasingly implicated not only in bacterial vaginosis (BV) but also in a broader range of infections. Despite growing recognition of its clinical relevance, comprehensive data on the characteristics of A. vaginae remain limited. This study aimed to isolate and thoroughly characterize the clinical strains of A. vaginae from both vaginal and oral cavity samples. A multifaceted methodological approach was employed, including antibiotic susceptibility testing to assess resistance and sensitivity profiles, PCR for genetic identification, and biochemical profiling using the VITEK-2 Compact system. Additionally, the morphological traits and growth dynamics of the isolates were examined. Given the established role of A. vaginae as a significant contributor to BV, the results of this study aim to support the development of evidence-based antimicrobial strategies for effective management of A. vaginae-associated infections.
1. Introduction and Short Bacteria Overview
Atopobium vaginae (so-called Fannyhessea vaginae) is a non-motile, non-spore forming, facultative anaerobic bacteria of the family Atopobiaceae (order Coriobacteriales, class Coriobacteriia, phylum Actinomycetota). The bacteria are Gram-positive and present as elliptical cocci or coccobacilli, often arranged in pairs or short chains [1,2,3,4]. Biochemically, it is primarily fermentative, producing lactic acid as the main end product on row with formic acid, and catalase-negative.
Atopobium (“strange living thing” from Greek) was first described in 1999, when isolated from the vagina of a healthy woman [4]. Since then, A. vaginae was considered to be part of the normal microflora of women’s reproductive systems; however, further research showed that the bacteria is associated with a number of pathological conditions such as tubo-ovarian abscess, salpingitis, and endometritis [5,6]; moreover, its high concentration leads to preterm birth [7]. The microbiological background of Atopobium-induced conditions are often accompanied with Gardnerella vaginalis, as have been described in cases of late miscarriage and prematurity [4]. The bacteria was also shown to play a role in «untypical» diseases, since it was isolated from the joints of 77-year-old woman who had a periprosthetic right-hip joint infection [8] and has also been identified as causing corneal infections [9]. These findings suggest that A. vaginae may possess unique mechanisms that enable it to colonize and persist in diverse niches, thereby contributing to its pathogenic potential. One such mechanism could be its ability to induce the expression of proinflammatory cytokines and chemokines in endometrial cells [10]. The resulting inflammatory response may lead to tissue damage and destruction, providing a plausible pathway through which A. vaginae exacerbates pathological conditions.
A. vaginae plays a pivotal and complex role in the development and progression of bacterial vaginosis (BV). The disease is often characterized with no pain, redness, or itching and there is only a shift to anaerobic microbiota [4]. According to Zhou et al., Gardnerella (37.12%), Prevotella (10.73%), and Atopobium (8.72%) are ranked as the top three pathogens in BV patients, and thus, highlighting their significant association with the condition compared to their lower prevalence in healthy individuals [11]. This disparity may be attributed to the role of Lactobacillus iners, a key component of the healthy vaginal microbiota, which has been shown to inhibit the growth of A. vaginae, thereby maintaining a balanced microbial environment [12,13]. However, when this protective balance is disrupted, A. vaginae may stimulate an immune response via Toll-like receptor 2, a mechanism that likely contributes to the inflammatory processes and microbial dysbiosis characteristic of BV (Figure 1) [4]. In addition to its immunomodulatory effects, A. vaginae contributes to BV pathogenicity through its involvement in biofilm formation. The polymicrobial BV biofilm, where A. vaginae frequently coexists with G. vaginalis, provides structural and metabolic protection that enhances bacterial survival and resistance to antibiotics. While G. vaginalis initiates biofilm development, A. vaginae acts as a secondary colonizer, contributing to the stability and pathogenicity of the mature biofilm. This synergistic interaction plays a crucial role in chronic infection and may explain the high recurrence rates of BV following treatment [4].
Figure 1.
Immune response pathways triggered by A. vaginae via Toll-like Receptors.
Toll-like receptor 2 (TLR2) is activated by recognizing specific bacterial components such as lipoproteins and peptidoglycans. This activation leads to the stimulation of phagocytic cells, including macrophages and neutrophils, and the production of pro-inflammatory cytokines like IL-1, IL-6, IL-12p70, IL-18, and TNF [12,13,14]. In the context of BV, pathogens such as A. vaginae can stimulate cells through TLR2, contributing to the inflammatory response. Studies have shown that the soluble factors present in the lower genital tract of women with BV activate cells via TLR2, indicating a pathway through which BV may cause adverse outcomes [15].
Furthermore, TLR2 activation can lead to the apoptosis of macrophages, which limits intracellular bacterial growth. For instance, in the case of Mycobacterium tuberculosis (Mtb), the TLR2 agonist LpqH activates autophagy and apoptosis in macrophages, restricting Mtb growth. The surface-exposed protein PE-PGRS33 of Mtb induces TNF production via TLR2 recognition and mediates macrophage apoptosis [11].
TLR2 is also localized in the epithelial cells of air passages, pulmonary alveoli, renal tubules, and Bowman’s capsules in renal corpuscles. The activation of TLR2 in epithelial cells can lead to the secretion of chemokines such as CXCL5, which attract neutrophils to the site of infection. For example, in pulmonary tuberculosis, neutrophil-driven destructive inflammation requires TLR2-mediated CXCL5 secretion from epithelial cells.
Thus, TLR2 activation plays a crucial role in recognizing pathogens and initiating immune responses, including the production of pro-inflammatory cytokines, the activation of phagocytosis, and the induction of apoptosis in infected cells.
The current therapeutic approach to BV primarily involves the administration of metronidazole or clindamycin. However, this strategy often results in high rates of disease recurrence, largely due to the inherent resistance of A. vaginae to metronidazole and, in some cases, to clindamycin. Furthermore, the use of clindamycin poses an additional challenge as it exhibits efficacy against beneficial Lactobacillus species, thereby disrupting the normal vaginal microbiota and potentially exacerbating microbial dysbiosis [16,17]. Interestingly, the therapeutic strategy can lead to shorter time of delivery [1]. A. vaginae was described as being sensitive to beta-lactams, so amoxicillin with clavulanic acid would be a better treatment of BV, thus may be used in clinical practice [18]. Regarding alternative antibiotics, azithromycin has been evaluated as a potential treatment for bacterial vaginosis. However, studies have consistently demonstrated its lack of efficacy against key pathogens associated with BV, including A. vaginae [1].
In summary, A. vaginae represents a highly intriguing subject for further investigation, given its involvement in a wide range of pathological conditions and the current gaps in understanding its antibiotic susceptibility and metabolic characteristics. Our study aims to provide a comprehensive analysis of A. vaginae while proposing evidence-based modifications to treatment protocols for gynecological and other Atopobium-associated infections. This research seeks to bridge critical knowledge gaps and contribute to more effective therapeutic strategies.
2. Materials and Methods
2.1. Culture Isolation and Growth Conditions
The isolation and identification of pathogens (7 vaginal samples and 5 oral isolates) were carried out in a certified microbiological laboratory of the Department of Microbiology at the Danylo Halytsky Lviv National Medical University, Ukraine. The clinical isolates were obtained from gynecological specimens collected at the Zhovkva Central District Hospital (Lviv region, Ukraine), while additional isolates were derived from oral cavity washings of healthy individuals. Swab samples were collected between 1 July and 30 November 2024. Swabs were collected from patients once. A bacteriological method was used to isolate a pure pathogen culture with MRS agar (HiMedia Ltd., Thane, India), 5% blood agar (Thermo Scientific™, Waltham, MA, USA) blood agar, glucose agar, and Endo agar (HiMedia Ltd., Thane, India). The bacterial culture grew under both aerobic (24 h) and anaerobic (48 h) conditions (vacuum method of creating anaerobic conditions).
2.2. Bacterial Identification and Biochemical Trials
The pathogen identification was performed using different methods. Some strains were identified with MIKRO-LA-TEST ANAERO kit (ErbaLachema, Brno-Řečkovice, Czechia) in five technical repetitions and using the corresponding codebook. Therefore, the VITEK-2 Compact (BioMérieux, Craponne, France) automatic system was used for detecting metabolism features of the A. vaginae in all (12) samples (VITEK 2 ANC card (Anaerobe and Corynebacterium Identification Card).
2.3. Antibiotic Sensitivity Test
Antibiotic sensitivity test was measured using disk diffusion method with interpretation according to Prevotella spp. according to EUCAST 2024 v 14.0, accessed 1 July 2024 (Figure 2) for 3 vaginal samples and 2 oral samples.
Figure 2.
A. vaginae stock culture on blood agar, cultivated in anaerobic conditions 48 h. Bacterial colonies can be described as smooth, white, and small in appearance.
2.4. PCR
PCR testing was performed for the third case.
Sample Collection and Preparation. Vaginal (7) and oral (5) swabs were collected from patients and placed in 1.5 mL tubes containing nuclease-free transport medium. The swabs were thoroughly vortexed for 15–20 s, and the sticks were removed at the designated breaking point, leaving the swab tips submerged in the medium. Samples were transported and stored at 2–8 °C for no longer than 24 h or at −20 °C for long-term storage until further processing.
DNA Extraction. DNA was isolated using the Sacace™ Bacterial Vaginosis Real-TM Quant kit (Sacace Biotechnologies, Como, Italy). Briefly, 300 µL of lysis buffer was added to each sample, followed by 100 µL of sample material. The mixture was incubated at 65 °C for 5 min. After centrifugation, 20 µL of sorbent was added to the mixture, followed by additional vortexing and incubation at room temperature. DNA was eluted in 100 µL of eluent buffer and either stored at 2–8 °C or directly used for amplification. According to the manufacturer’s instructions for the Sacace™ Bacterial Vaginosis Real-TM Quant kit, the amplification utilizes the “PCR-mix-1-FRT” and “PCR-mix-2” reagents, which include all necessary components, such as primers and probes specifically designed for A. vaginae DNA. Detection of A. vaginae was performed in the JOE/Yellow/HEX/Cy3 fluorescence channel.
Real-Time PCR Amplification. Quantitative detection of A. vaginae, Gardnerella vaginalis, Lactobacillus spp., and total bacterial load was performed using the RotorGene 6000 real-time thermal cycler (Qiagen, Hilden, Germany). Each 25 µL reaction mixture contained 15 µL of PCR master mix and 10 µL of extracted DNA. Positive and negative controls were included in each run to ensure assay validity. The thermal cycling protocol was as follows: initial denaturation: 95 °C for 15 min; 5 cycles: 95 °C for 5 s, 60 °C for 20 s, 72 °C for 15 s; 40 cycles: 95 °C for 5 s, 60 °C for 20 s (fluorescence detection step), 72 °C for 15 s. The fluorescence signal for A. vaginae was detected in the JOE/HEX/Cy3 channel.
3. Results
This study consists of several stages aimed at characterizing bacteria isolated from clinical and non-clinical samples. A common clinical complaint among the gynecological cases was the presence of atypical white vaginal discharge accompanied by an unpleasant odor (unstable peanut odor mixed with a “fishy” odor).
Initial isolation procedures revealed that A. vaginae presented as Gram-positive cocci, notably smaller in size than typical cocci. Remarkably, visible growth was observed after 24 h of incubation under aerobic conditions. Several culture media were assessed for suitability, including glucose agar, MRS medium, and blood agar (Figure 2), all of which supported bacterial growth. Growth on Endo medium, however, was strain-dependent—some strains grew well, while others did not.
Colonies of A. vaginae were generally smooth, white, and small in appearance. Colony density varied between strains, but all exhibited a characteristic yogurt-like odor. As the isolation procedure progressed, the bacteria adapted to laboratory conditions, which was accompanied by notable changes in morphology (Figure 3).
Figure 3.
Light microscopy of A. vaginae (Gram staining, 10 × 100 magnification). Gram-positive bacteria (1) located in pairs or short chains (2). Clinical strains can be Gram-variable.
To further characterize the isolates, coagulase and oxidase tests were performed. The isolates demonstrated positive coagulase activity and negative oxidase activity.
Antibiotic sensitivity tests were performed for most antibiotic groups and according to EUCAST antibiotic standards for Prevotella spp. Per the latest EUCAST guidelines, Prevotella spp. is a Gram-negative anaerobe occupying niches similar to A. vaginae and is often found in related pathologies. Importantly, EUCAST does not provide antibiotic sensitivity standards for A. vaginae.
A. vaginae is sensitive to Macrolide, Oxazolidinones, Chloramphenicol and resistant to penicillin, cephalosporins, fluoroquinolone, tetracycline, carbapenem, and lincosamide. Other antibiotic groups cannot be estimated properly; however, beta-lactamase inhibitors seem to be efficient against the bacteria and metronidazole and sulfanilamides have no effect at all. The analysis is demonstrated in Figure 4.
Figure 4.
Comparison of the effect of different antibiotic groups on A. vaginae. Results are made by calculating the average number of zone of inhibition (in mm). Red lines represent sensitivity standards for Prevotella spp. according to EUCAST, which means A. vaginae is the most sensitive to macrolide, oxazolidinones, and chloramphenicol.
Among basic antibiotic groups, the most effective substances can be outlined. Piperacillin (ureidopenicillins), cefuroxime (2nd generation of cephalosporins), imipenem (carbapenems), and moxifloxacin (fluoroquinolones) can be stated as the best antibiotics of their classes. Detailed information of the effectiveness of each tested antibiotic against A. vaginae is shown in Table 1. Remarkably, the bacteria can be sensitive as well as resistant to amoxicillin, cefazolin, doxycycline, levofloxacin, and to clindamycin.
Table 1.
Complete analysis of the inhibitory activity of various antibiotics. Zones of inhibition (in mm) are presented according to bacterial strain and the mechanism of action of each antimicrobial agent.
The next stage concerns studying the metabolic features of A. vaginae. The bacteria ferments carbs (cellobiose, fructose, lactose); additionally, it interacts with/synthesizes carb-derived substances (inositol, ß-galactosidase, malonate, adonitol, ß-glucosidase, N-acetyl-D-glucosamine, ribose, salicin, arbutin). A. vaginae has high activity of leucine arylmidase, phenylalanine arylmidase, and l-proline arylmidase and characterizes with no other protein metabolism. Detailed statistics are shown in Table 2.
Table 2.
Representation of fermentative features of A. vaginae performed with MIKRO-LA-TEST (A, B; the samples are taken from vagina) and VITEK-2 (C; the bacteria was taken from oral cavity). d—variable results. Variable—ESC/ESL, URE, MNE/MAN, GLU, VPT.
4. Discussion
This study provides a characterization of the clinical isolates identified as A. vaginae, obtained from both vaginal samples associated with clinical complaints typical of bacterial vaginosis (BV) and, notably, from oral cavity washings of healthy individuals. Our data are consistent with other studies [4] regarding the variability in the morphological and biochemical characteristics. Our results indicate that A. vaginae is resistant to metronidazole and, in some cases, to clindamycin. This is consistent with the findings of De Backer et al. (2006) [19], who showed that clindamycin may have limited efficacy against A. vaginae. Thus, our study confirms the need to expand antibiotic therapy beyond conventional BV protocols. Sensitivity tests indicate the efficacy of beta-lactams such as amoxicillin with clavulanic acid, which may be more resistant to relapse in patients with BV [18].
Through clinical cases and some reviewed data, it can be stated that A. vaginae mostly grow with Gardnerella vaginalis, though it was shown to grow with Candida spp. as well., which is consistent with the data of Zhou et al. (2022), who identified A. vaginae as one of the three main pathogens in BV [12].
Our observations highlight the variability in antibiotic resistance of A. vaginae depending on the strain (sensitivity to doxycycline, amoxicillin, levofloxacin, clindamycin, Table 1), which may indicate the presence of genetic variability and resistance that is formed under the influence of different environmental conditions. This is an important limitation for universal approaches to the therapy of A. vaginae-induced infections, and these features require further research (Caselli et al., 2019) [10]. Interestingly, clindamycin, which is used for BV therapy, can affect the bacteria and can have no effect [19], which was also proved in our study.
Talking about special features of bacterial identification, antibiotic sensitivity, PCR- tests may be more convenient for detecting A. vaginae culture, since culture and even staining morphology as well as metabolic characteristics varies from strain to strain.
While the genus Atopobium includes species known to inhabit the oral cavity (e.g., A. rimae, A. parvulum), often associated with periodontal disease or caries, F. vaginae itself is not typically considered a common resident of the healthy human oral microbiome but is listed in the Human Oral Microbiome Database (HOMD). The presence of A. vaginae in the healthy oral cavity, if confirmed through robust identification methods like sequencing, could signify a broader commensal range than previously appreciated. This raises important questions regarding its role in the oral environment (transient vs. stable colonizer) and its potential as a reservoir for transmission to the genitourinary tract, potentially via practices like oral sex, which has been identified as a risk factor for BV [19].
This trial was registered at ClinicalTrials.gov, managed by the US National Institutes of Health (NIH) and a division of the National Library of Medicine (NLM). ClinicalTrials.gov ID: NCT06616168. Hyperlink: https://clinicaltrials.gov/study/NCT06616168, accessed on 11 March 2025.
This study has several limitations that should be considered. A. vaginae strains were difficult to passage, despite the fact that they were grown under aerobic and anaerobic conditions. We planned to carry out identification on MALDI-TOF, but most of the strains did not pass during re-culture. In this regard, out of 12 Atopobium strains, it was possible to determine antibiotic sensitivity only for 2 strains, and biochemical properties only for 3 strains out of 12. The limitation was also not in the determination of MIC, but the determination of sensitivity only via the disk diffusion method, including the difficulty of cultivation. Finally, the limited sample size and single-center origin of clinical specimens may restrict the generalizability of the findings.
5. Conclusions
In conclusion, this study contributes to the characterization of A. vaginae, reinforcing its association with BV and highlighting phenotypic heterogeneity and an antibiotic resistance profile, notably, marked resistance to metronidazole and variable susceptibility to clindamycin. The preliminary observations of potential aerobic tolerance and presence in the healthy oral cavity warrant further investigation. At this stage, several suggestions for managing Atopobium-associated BV have been proposed based on antibiotic susceptibility profiles. However, the absence of standardized EUCAST criteria specific to A. vaginae and the observed strain-dependent variability highlight the importance of future clinical trials to validate effective therapeutic strategies and to establish clear diagnostic and treatment guidelines. The main diagnostic method remains PCR directly from a vaginal swab, without isolating a pure culture.
Author Contributions
Conceptualization, A.V.; methodology and experimental work, A.V., S.N., H.L. and A.S.; data analysis, Y.K., S.N., R.K. and H.L.; writing—review and editing, A.V., A.S. and Y.K.; project administration and supervision, Y.K. All authors have read and agreed to the published version of the manuscript.
Funding
The research leading to these results has received funding from the Ministry of Health of Ukraine, under the project number 0123U100153, and grants of the National Research Foundation of Ukraine 2023.03/0104; 2023.05/0021.
Institutional Review Board Statement
This study was conducted in accordance with the Declaration of Helsinki, and approved by the Institutional Review Board. Permission to conduct experiments on animals and isolate/work with cultures of microorganisms was approved by protocol No. 13, 15 December 2023 of the Commission on Ethics of Scientific Research, Experimental Development, and Scientific Works of Danylo Halytsky LNMU, Ukraine.
Informed Consent Statement
Written informed consent was obtained from the patient(s) for publication and any accompanying images. A copy of the written consent is available for review by the Editor-in-Chief of this journal on request. Written informed consent has been obtained from the patient(s) to publish this paper.
Data Availability Statement
Data are contained within the article.
Acknowledgments
We thank the Armed Forces of Ukraine for being able to develop science, even during the war.
Conflicts of Interest
The authors declare no conflicts of interest.
Abbreviations
| BV | Bacterial Vaginosis |
| PCR | Polymerase Chain Reaction |
| TLR2 | Toll-Like Receptor 2 |
| IL | Interleukin |
| TNF | Tumor Necrosis Factor |
| EUCAST | European Committee on Antimicrobial Susceptibility Testing |
| MRS | De Man, Rogosa, and Sharpe |
| MIC | Minimum Inhibitory Concentration |
| LNMU | Lviv National Medical University |
| CFU | Colony-Forming Unit |
| ANAERO | Anaerobic |
| DNA | Deoxyribonucleic Acid |
| RNA | Ribonucleic Acid |
| NCT | National Clinical Trial |
| NIH | National Institutes of Health |
| NLM | National Library of Medicine |
References
- Jordan, V.; Akram, A.; Pickles, R.; Arnold, A.; Naqvi, S. Fannyhessea vaginae Causing Bacteraemia and Vertebral Osteomyelitis: First Report of Invasive Disease in a Male. Access Microbiol. 2024, 6, 000785.v3. [Google Scholar] [CrossRef] [PubMed]
- Nouioui, I.; Carro, L.; García-López, M.; Meier-Kolthoff, J.P.; Woyke, T.; Kyrpides, N.C.; Pukall, R.; Klenk, H.P.; Goodfellow, M.; Göker, M. Genome-Based Taxonomic Classification of the Phylum Actinobacteria. Front. Microbiol. 2018, 9, 2007. [Google Scholar] [CrossRef]
- Chan, J.F.W.; Lau, S.K.P.; Curreem, S.O.T.; To, K.K.W.; Leung, S.S.M.; Cheng, V.C.C.; Yuen, K.Y.; Woo, P.C.Y. First Report of Spontaneous Intrapartum Atopobium vaginae Bacteremia. J. Clin. Microbiol. 2012, 50, 2525–2528. [Google Scholar] [CrossRef]
- Mendling, W.; Palmeira-de-Oliveira, A.; Biber, S.; Prasauskas, V. An Update on the Role of Atopobium vaginae in Bacterial Vaginosis: What to Consider When Choosing a Treatment? A Mini Review. Arch. Gynecol. Obstet. 2019, 300, 1–6. [Google Scholar] [CrossRef] [PubMed]
- Knoester, M.; Lashley, L.E.E.L.O.; Wessels, E.; Oepkes, D.; Kuijper, E.J. First Report of Atopobium vaginae Bacteremia with Fetal Loss after Chorionic Villus Sampling. J. Clin. Microbiol. 2011, 49, 1684–1686. [Google Scholar] [CrossRef] [PubMed]
- Geißdörfer, W.; Böhmer, C.; Pelz, K.; Schoerner, C.; Frobenius, W.; Bogdan, C. Tuboovarian Abscess Caused by Atopobium vaginae Following Transvaginal Oocyte Recovery. J. Clin. Microbiol. 2003, 41, 2788–2790. [Google Scholar] [CrossRef] [PubMed]
- Bretelle, F.; Rozenberg, P.; Pascal, A.; Favre, R.; Bohec, C.; Loundou, A.; Senat, M.V.; Aissi, G.; Lesavre, N.; Brunet, J.; et al. High Atopobium vaginae and Gardnerella vaginalis Vaginal Loads Are Associated with Preterm Birth. Clin. Infect. Dis. 2015, 60, 860–867. [Google Scholar] [CrossRef] [PubMed]
- Massa, B.; De Laere, E.; Raes, R.; Vervaeke, S.; Van Hoecke, F. First Report of a Prosthetic Joint Infection with Fannyhessea (Atopobium) Vaginae. Eur. J. Clin. Microbiol. Infect. Dis. 2022, 41, 1023–1027. [Google Scholar] [CrossRef] [PubMed]
- Singh, N.K.; Sahu, S.; Priyadarshini, S.R.; Behera, H.S. First Reported Case of Corneal Infection Caused by Atopobium vaginae. BMJ Case Rep. 2022, 15, e248988. [Google Scholar] [CrossRef] [PubMed]
- Caselli, E.; Soffritti, I.; D’Accolti, M.; Piva, I.; Greco, P.; Bonaccorsi, G. Atopobium vaginae and Porphyromonas somerae Induce Proinflammatory Cytokines Expression in Endometrial Cells: A Possible Implication for Endometrial Cancer? Cancer Manag. Res. 2019, 11, 8571–8575. [Google Scholar] [CrossRef] [PubMed]
- Numanovic, N.; Ribis, S.; Cukic, J.; Nenadic, D.; Zivanovic, A.; Sazdanovic, P.; Ninkovic, V.; Baskic, D. Quantification of Gardnerella vaginalis, Atopobium vaginae and Lactobacillus spp. in Bacterial Vaginosis. J. Infect. Dev. Ctries. 2021, 15, 1293–1298. [Google Scholar] [CrossRef] [PubMed]
- Zhou, R.; Lu, J.; Wang, J.; Xiao, B. Vaginal Lactobacillus iners Abundance Is Associated with Outcome in Antibiotic Treatment of Bacterial Vaginosis and Capable of Inhibiting Gardnerella. Front. Cell. Infect. Microbiol. 2022, 12, 1033431. [Google Scholar] [CrossRef] [PubMed]
- Abou Chacra, L.; Fenollar, F.; Diop, K. Bacterial Vaginosis: What Do We Currently Know? Front. Cell. Infect. Microbiol. 2022, 11, 672429. [Google Scholar] [CrossRef] [PubMed]
- Libby, E.K.; Pascal, K.E.; Mordechai, E.; Adelson, M.E.; Trama, J.P. Atopobium vaginae Triggers an Innate Immune Response in an in Vitro Model of Bacterial Vaginosis. Microbes Infect. 2008, 10, 439–446. [Google Scholar] [CrossRef] [PubMed]
- Mares, D.; Simoes, J.A.; Novak, R.M.; Spear, G.T. TLR2-Mediated Cell Stimulation in Bacterial Vaginosis. J. Reprod. Immunol. 2008, 77, 91–99. [Google Scholar] [CrossRef] [PubMed]
- Lamont, R.F.; Hnan-Chang, C.L.; Sobel, J.D.; Workowski, K.; Conde-Agudelo, A.; Romero, R. Treatment of Abnormal Vaginal Flora in Early Pregnancy with Clindamycin for the Prevention of Spontaneous Preterm Birth: A Systematic Review and Metaanalysis. Am. J. Obstet. Gynecol. 2011, 205, 177–190. [Google Scholar] [CrossRef] [PubMed]
- Eade, C.R.; Diaz, C.; Wood, M.P.; Anastos, K.; Patterson, B.K.; Gupta, P.; Cole, A.L.; Cole, A.M. Identification and Characterization of Bacterial Vaginosis-Associated Pathogens Using a Comprehensive Cervical-Vaginal Epithelial Coculture Assay. PLoS ONE 2012, 7, e50106. [Google Scholar] [CrossRef] [PubMed]
- Dauby, N.; Martiny, D.; Busson, L.; Cogan, A.; Meghraoui, A.; Argudín, M.A.; Nonhoff, C.; Hallin, M.; Konopnicki, D. Atopobium vaginae Intrapartum Bacteremia: A Case Report with a Literature Review. Anaerobe 2019, 59, 212–214. [Google Scholar] [CrossRef] [PubMed]
- Brotman, R.M. Vaginal Microbiome and Sexually Transmitted Infections: An Epidemiologic Perspective. J. Clin. Investig. 2011, 121, 4610–4617. [Google Scholar] [CrossRef] [PubMed]
Disclaimer/Publisher’s Note: The statements, opinions and data contained in all publications are solely those of the individual author(s) and contributor(s) and not of MDPI and/or the editor(s). MDPI and/or the editor(s) disclaim responsibility for any injury to people or property resulting from any ideas, methods, instructions or products referred to in the content. |
© 2025 by the authors. Licensee MDPI, Basel, Switzerland. This article is an open access article distributed under the terms and conditions of the Creative Commons Attribution (CC BY) license (https://creativecommons.org/licenses/by/4.0/).